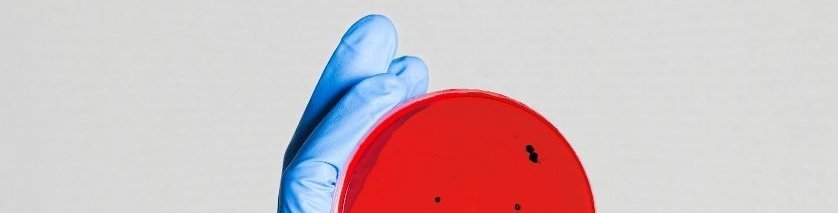
A lab scientist in gloves holding up a blood agar plate with bacteria growth on it.

-
Workflow Solutions
Discover our and our partners ready-to-go workflows
-
Markets
Find solutions for your daily analytical challenges
-
Sample Prep & Injection
Seemless capabilities of the PAL System
-
Products
Automated Sample Preparation
-
Content Hub
Search our library for news - app notes, videos, webinars, brochures, manuals and many more
-
Newsroom
Discover the latest updates, expert insights, and in-depth resources in the world of lab automation
-
PAL Solutions
PAL Experts - Delivering comprehensive services around the PAL Platform
-
Contacts
Discover our global network